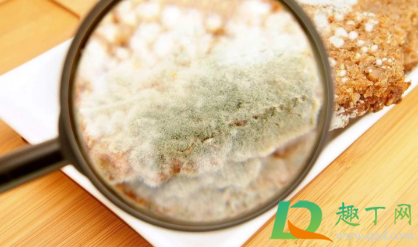
餐具黄曲霉菌用水能洗掉吗(被黄曲霉菌污染的厨具)

餐具黄曲霉菌用水能洗掉吗(被黄曲霉菌污染的厨具)
永远没有人力可以击退一个坚决强毅的希望。——金斯莱
许彦霖网友提问:
餐具黄曲霉菌用水能洗掉吗
优质答案:
淀粉类食品发霉还有碗筷发霉是很轻易有黄曲霉素的,所以食品一定要保存好,碗筷也要彻底清洗干净之后沥干水分。假如食品发霉了最好就不要食用了,碗筷也最好避免木筷子或者竹筷子,选择不易长霉的材质。黄曲霉素是一种很顽固的细菌,水洗、高温都不能拿它怎么样。

餐具黄曲霉菌用水能洗掉吗
餐具上的黄曲霉菌,皮肤上的细菌和黄曲霉菌,尤其是手上的黄曲霉菌,不能单独用水甚至洗洁剂洗净。 黄曲霉毒素难溶于水,可被200度以上的高温杀死。 洗碗液不能杀死黄曲霉毒素。建议在消毒之前使用清洁剂清洁表面的油渍。 可以将其浸进84消毒液中半小时。 84的氧化性质可以破坏黄曲霉毒素的有机结构并降低毒性。

黄曲霉菌怕紫外线吗
紫外线可以抑制黄曲霉菌,但不能破坏黄曲霉毒素。 黄曲霉毒素不易溶于水,具有耐热性,强耐酸性,并且可以抵抗紫外线。 因此,阳光不能杀死黄曲霉毒素。 当然,面对黄曲霉毒素,消毒柜是无奈的。但是,有一些方法可以杀死或往除一些黄曲霉毒素。 由于黄曲霉毒素在碱性条件下相对轻易分解,因此在小苏打(1%的碳酸氢钠)中浸泡一段时间可以往除90%以上的黄曲霉毒素。 另外,高压锅的压力较高,温度较高,黄曲霉毒素的往除效果较好。
黄曲霉具有剧毒。 它可以引起肝癌或胃癌,并且毒性很大。 一定不要吃一些发霉的食品,最好不要吃一些发霉的大米,发霉的大豆,这些粮食作物不能食用。
怎么阔别黄曲霉素
1.将花生油等食用油倒进锅中并加热,加进少量盐,然后搅拌10-20秒。这将基本消除食用油中的大部分黄曲霉毒素。用食盐中和和降解黄曲霉毒素可以消除95%的黄曲霉毒素。2.多吃绿叶蔬菜可以使我们意外地吃掉一部分黄曲霉毒素,由于叶绿素可以阻止黄曲霉毒素的吸收并预防肝癌。
3.除食品外,生活中的很多事物都可能被黄曲霉毒素污染。经常洗手是阔别毒素的最基本方法。
4.不要尽可能多储存食品。食品应存放在低温,透风干燥的地方,以防止发霉的食品产生黄曲霉毒素。购买食品时,假如发现包装不干净或损坏,请勿购买。尝试选择小包装的坚果。
5.黄曲霉不一定发霉,但很多霉菌对身体有害,因此请果断丢弃。请勿用水冲洗或取出模具零件。这是不可接受的,由于黄曲霉中毒只需要一点点就可以中毒。肉眼看不见的东西不一定没有毒素。
6.吃坚果的时候勤奋一点,用手往壳,不要用嘴啃。不要吃变质的东西,并尽量减少黄曲霉的污染。

以上就是黄曲霉,毒素,黄曲霉菌的相关信息资料了,希望能帮到您。人的一生只有一次青春。——朗费罗
有了母亲在身边,我们不必去寻求别人。她对我们的教诲是非常宝贵的:和善友爱体贴别人居于首位;不要伤害别人;决不乞求;决不占别人的便宜。与之相反的做法在我们家都是罪过。她总是要我们给予,但她从不要我们索取或乞求。她就是这样的人。迈克尔•杰克逊
大多数人想要改造这个世界,但却罕有人想改造自己。












